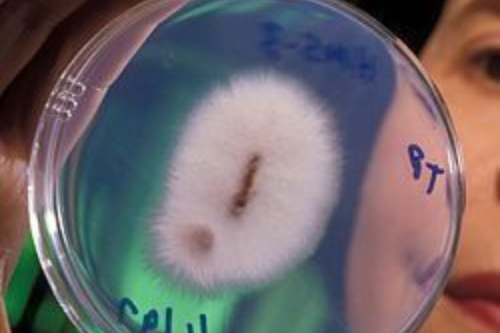
hongo Además del banano, este tipo de hongos ha comenzado a mostrar resistencia a los fungicidas tradicionales, lo que complica aún más el control (Pinterest)

Así actúa el hongo que está arrasando cultivos en Latam: una nueva amenaza silenciosa pone en jaque a la agricultura regional. Se trata de un fungi altamente agresivo que ya afecta a múltiples países de América Latina, generando pérdidas millonarias y preocupación en el sector agrícola.
Una amenaza que crece bajo tierra
El cambio climático, el aumento de temperaturas y la sobreexplotación de la tierra han creado el escenario perfecto para la expansión de hongos patógenos que atacan cultivos esenciales como el banano, el café, el trigo y el maíz. Uno de los más peligrosos es el Fusarium oxysporum, conocido por causar la devastadora enfermedad de Panamá, que ya afecta plantaciones de banano en Colombia, Perú y otros países.
¿Qué cultivos están en riesgo?
Te puede interesar- Revolución verde: crean film comestible con yerba mate

Además del banano, este tipo de hongos ha comenzado a mostrar resistencia a los fungicidas tradicionales, lo que complica aún más el control. Cafetales en Centroamérica y Sudamérica también han reportado brotes, al igual que cultivos de cereales y hortalizas que son base de la alimentación en la región.
Los brotes fúngicos no solo ponen en peligro la seguridad alimentaria, sino que también generan pérdidas millonarias para los productores y fomentan la deforestación, al obligar a trasladar los cultivos a nuevas zonas. Además, el uso intensivo de químicos para combatirlos puede afectar la biodiversidad y los suelos.
¿Qué se está haciendo para frenarlo?
Organizaciones internacionales como la FAO y científicos locales trabajan en nuevas estrategias de detección temprana, rotación de cultivos, biotecnología y hongos benéficos que ayuden a frenar la expansión. Aun así, muchos expertos coinciden: la prevención y la transición hacia una agricultura regenerativa son clave para proteger los alimentos del futuro.
Global